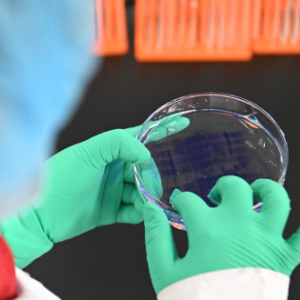

医保药品,牵动万家。
最新版医保药品目录已于2026年1月1日正式落地实施。此次调整有哪些新亮点?为参保人带来哪些利好?国家医保局7日进行了解读。
聚焦临床急需,1类新药数量创新高——目录新增114种药品,50种为1类新药。
“无论是比例还是数量,均创历年新高。”国家医保局医药服务管理司司长黄心宇说。新增药品涵盖肿瘤、罕见病、慢性病等。
2025年2月20日,一家药企实验人员在检验生物制品蛋白分子量。新华社记者 孙凡越 摄
一批备受关注的新药顺利“入保”:如用于治疗三阴性乳腺癌的芦康沙妥珠、胰腺癌用药伊立替康脂质体等;用于改善内源性生长激素缺乏所致儿童生长缓慢的长效生长激素针;一年两针的降血脂针英克司兰钠、糖尿病用药替尔泊肽等新药;流感用药昂拉地韦片、玛舒拉沙韦片等。
支付范围“再扩围”,“救命药”更快更可及——65种药品的支付范围有了新变化。
梳理可以发现,不少药品的新增适应症被纳入支付范围,如治疗非小细胞肺癌的阿美替尼片新增两个新靶点、治疗罕见病发作性睡病的盐酸替洛利生片拓展至6岁及以上患者、曲普瑞林新增子宫内膜异位症等,符合条件的参保人可享受相关待遇。
为方便临床用药,用于提升白细胞数量的拓培非格司亭注射液等药品,支付范围从“前次化疗”调整为“既往化疗”,更贴近临床实际,还有一些集采药品取消支付范围标注,根据药品说明书即可。
针对少数药品的滥用风险,目录新增限定条件,如明确烟酰胺仅限烟酰胺缺乏症患者可报销,确保医保基金用在“刀刃上”。
一些药品的支付范围删减非核心限定内容,但并不改变用药要求。如糖尿病用药司美格鲁肽,删除了“在运动和饮食控制基础上”,调整后临床医生仍需根据药品说明书用药。

国家医保局微信公众号已上线新版基本医保目录查询功能。(图片来自国家医保局)
动态“吐故纳新”,目录结构更合理——调出29种药品,均为已被临床淘汰、或长期未生产供应的药品。
其中包括贝那鲁肽注射液、达诺瑞韦钠片、盐酸拉维达韦片、阿利西尤单抗注射液、度维利塞胶囊、八氟丙烷脂质微球注射液、甘露特钠胶囊、林普利塞片等8种未成功续约调出目录的谈判药品。
为保障参保人用药连续性,国家医保局设置过渡期政策,此次调整中未成功续约被调出目录的协议期内谈判药品有6个月的过渡期,2026年6月底前,参保人购买这些药品,仍然可按照原报销标准。
目前,国家医保局微信公众号已上线新版基本医保目录查询功能。参保人进入“国家医保局”微信公众号,点击“医保服务”,选择“基本医保目录查询”即可。
策划:陈芳
记者:彭韵佳
统筹:王敏、吴晶
新华社国内部出品